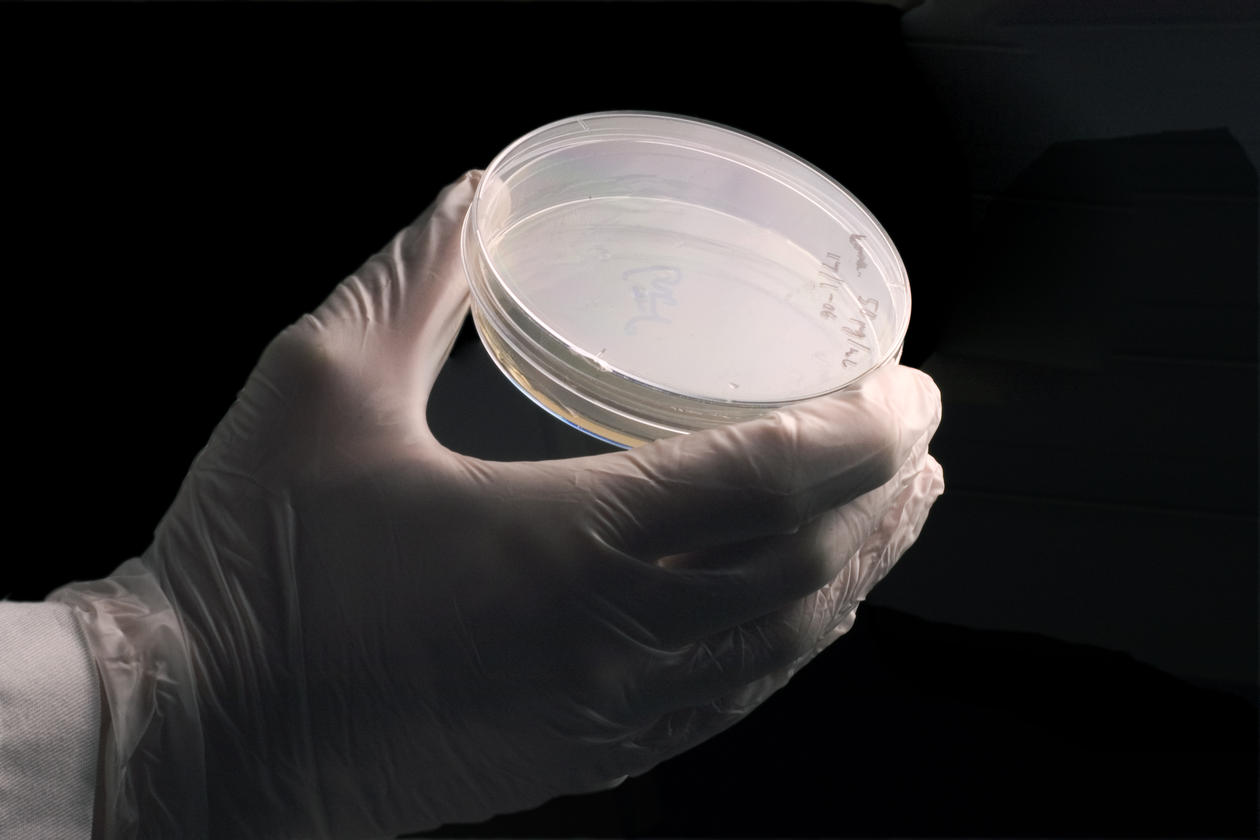

Laboratory Methods
Below are some methods frequently used at PROBE. You are welcome to download these methods for use in your own laboratory.
Main content
BCA Assay
This assay does not tolerate agents like DTT, TCEP, GSH and beta-mercaptoethanol. For reducing agents, use the Bradford assay or the reducing agent compatible BCA assay. It does however tolerate SDS and other ionic detergents. For more information, check the “Protein quantitation assay compatibility table”.
An excel template for calculating the protein amount is available. To use it, click "File" and "Download a copy" or "Save As".
In-Gel Digestion
The gel-lanes cut from the gel must be divided in 1 x 1 mm cubes, and transferred to an 1.5 ml eppendorf tube. Cover the gel with water, and store in fridge until further processing. The protocol involves extraction of SDS and stain from the gel followed by in-gel reduction and alkylation of cysteins, trypsin digestion, and peptide extraction and purification on nC18 RP-microcolumns or OASIS desalting plates (Oasis HLB 96-well µElution Plate, 2 mg Sorbent per Well).
In-Solution Digestion; 6M Guanidine-HCl
Guanidine hydrochloride (Gnd-HCl) is a charged chaotropic agent and hydrogen bonds and hydrophilic interactions enabling proteins to unfold with all ionizable groups exposed to solution. Gdn-HCl does not cause obvious artifacts during high temperature (incubating samples in Gnd-HCl for up to one hour at 95 °C generally improved the overall number of protein identifications). Be aware that Gnd-HCl is a trypsin inhibitor, and it will be necessary to reduce the concentration to about 1M before adding trypsin. Long digestion times also increase the number of artefacts, mainly deamidation of asparagine and N-terminal glutamine cyclization of proteins/peptides. Solutions are stable over normal working pH ranges—i.e., pH 2.0 to 10.5
In-Solution Digestion, 8M Urea
Urea is a chaotropic agent and disrupts the three dimensional structure of proteins promoting denaturation. However, urea + heat + protein = carbamylation; urea in solution is in equilibrium with ammonium cyanate, that may decompose to ammonia and isocyanic acid (HNCO). Isocyanic acid attach the N-terminal of the protein, but also the side chains of lysine and arginine residues rendering a protein unsuitable for many enzymatic digests. Urea will degrade to isocyanic acid, so urea solutions must be made fresh, and it is recommended to add 20mM methylamine (CH3NH2) to the urea solution (scavenger for isocyanic acid) prior to use.
In-Solution Digestion, FASP (single protease)
With FASP you can use detergent based lysis buffers for preparation of samples for LC-MS/MS. There is an approximate 30-50% loss of protein with this procedure. In a single filter device (Microcon YM-30, Millipore #MRCF0R030) 0.2-200 µg (max 300 µg) protein can be processed.
In-Solution Digestion; SP3
SP3, Single-pot, solid-phase-enhanced sample Preparation.
Sera-Mag SpeedBeads, 50mg/ml (GE Healthcare, cat. no. 45152105050250)
Sera-Mag SpeedBeads, 50mg/ml (GE Healthcare, cat. no. 65152105050250)
SpeedBeads, Carboxylate-Modified Magnetic Particles combine a fast magnetic response time and high binding capacity with a large surface area, high sensitivity, stability, physical integrity, and fast reaction kinetics. Covalent coupling of biomolecules such as proteins and nucleic acids to carboxyl groups on the surface is easily accomplished. The two beads have different levels of hydrophobicity/hydrophilicity
In-Solution Digestion, conditioned Medium; Secretome analysis
Cell culture, harvesting secreted proteins in conditioned medium. To avoid additives that may interfere with downstream proteomics analysis (ex. FBS) it is of vital importance that the cell medium is purchased without these additives.
On-Bead Digestion (immunoprecipitate)
Protocol starts after an IP have been performed in precleared lysate (lysed in immunoprecipitation buffer, ex NEB buffer: 50mM NaCl, 10mM Tris-HCl pH 7.4, 1mM EDTA, 1mM EGTA pH 8.0, 0.2 mM sodium ortho-vanadate (phosphatase inhibitor, 0.2M Phenylmetanesulfonyl fluoride (serine protease inhibitor), 1% Triton, 0.5% NP-40), adding Protein A/G Magnetic Beads, and beads washed 3 times with immunoprecipitation buffer.
Peptide Desalting, OASIS 96-well plates
The Oasis HLB 96-well plate contains the Oasis HLB sorbent, which is a universal polymeric reversed-phase sorbent that was developed for the extraction of a wide range of acidic, basic, and neutral compounds from various matrices. This sorbent has been found to retain ionized analytes more strongly than silica-based RP sorbents.
Phospho-peptide Enrichment; Ti-IMAC
MagReSyn Ti-IMAC (immobilized metal affinity chromatography using titanium ions) is a proprietary magnetic polymeric microparticle support that provides a simple, convenient, efficient and specific method of phosphopeptide enrichment from e.g. trypsin digested protein mixtures. The product consists of titanium ions (Ti4+)chelated to the ReSyn polymer microparticles. The superior features of the polymer technology have been harnessed to engineer a highly specific product for the enrichment of
phosphopeptides suitable for mass spectrometry-based proteomics applications
TMT-Labelling
Protein extracts isolated from cells or tissues are reduced, alkylated, and digested. Samples are labeled with TMT or TMTpro reagents and then mixed before sample fractionation and clean-up. Labeled samples are analyzed by high resolution Orbitrap LC-MS/MS before data analysis to identify peptides and quantify reporter ion relative abundances.